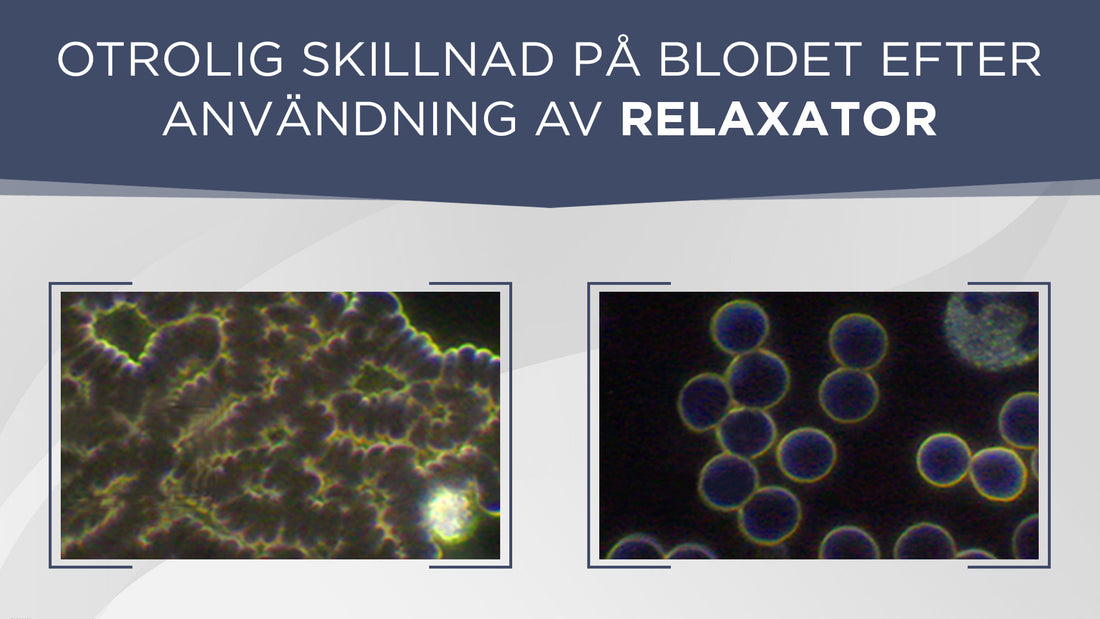

Otrolig skillnad på blodet med relaxator
Toni Dicks har jobbat med levande blodanalys i flera år, vilket innebär att man tar en ögonblicksbild av blodet. I sitt arbete har hon hjälpt många människor förbättra sin hälsa. Efter att ha gått kursen i Medveten Andning har några av Tonis klienter fått testa Relaxatorn. Bilderna från de tre klientfallen nedan bekräftar att resultaten är enastående. Toni har aldrig sett en sådan kraftfull förbättring av syresättningen i blodet som efter andningsträning med Relaxatorn.
Klientfall 1 (Jag – Anders Olsson)
Före. Toni: –De röda blodkropparna är sammanbundna på grund av syrebrist och uttorkning. De vita blodkropparna är små, grå och stillastående.
Efteråt. Toni: –Fantastiskt blod med positivt laddade röda blodkroppar och ett starkt lyster runt cellmembranen. Titta på kvalitén på de via blodkropparna nu! Exceptionella resultat efter att ha andats 20 minuter i Relaxatorn.
Klientfall 2
Före. Toni: –Många av de röda blodkropparna har ett ihåligt centrum, vilket innebär att syrenivåerna är låga. Trots mycket arbete med denna klient har hennes röda blodkroppar svårt att få till ett bra gasutbyte.
Efteråt. Toni: –Inga ihåliga celler efter 60 minuters andningsträning med Relaxator. De vita blodkropparna är större och rör sig snabbare.
Klientfall 3
Före. Toni: –De röda blodkropparna har ett ihåligt center, en toxisk glans (gulaktig färg) och är fastklibbade i varandra. Trots mycket arbete med denna klient har hon fortfarande inte förmåga att hålla kvar syret på cellnivå.
Efteråt. Toni: –Efter 60 minuters andningsträning med Relaxatorn är de vita blodkropparna större och rör sig. De röda blodkropparna är positivt laddade och har absorberat syre. Otroliga resultat!!!
OBS! Levande blodanalys är ingen exakt vetenskap och det finns många olika sätt att tolka ovanstående bilder på. MEN, samtidigt är bilderna väldigt inspirerande och får oss att enkelt inse att vi har alla möjligheter att påverka vår inre miljö på ett positivt sätt. Denna insikt kan för många människor vara första steget mot att ta ökat ansvar för sin hälsa och sitt liv. Anders Liåker blev inspirerad av bilderna och du kan läsa hans berättesle här Kraftigt förbättrad blodcirkulation med andningsträning.
Bilderna bekräftar också att vår andning har den allra största påverkan på vårt blod, nämligen:
- Koldioxid är bakteriedödande Förbättrad andning leder till ökade nivåer av koldioxid i blodet (förutom vid KOL och lungemfysem, då nivåerna redan är höga på grund av förstörd lungvävnad). Koldioxid är bakteriedödande, vilket är anledningen till att bröd, kaffe, ost mfl livsmedelsprodukter förpackas i 100% koldioxid sedan 1930-talet.
- Koldioxid vidgar blodkärl Vidare har koldioxid en vidgande och avslappnade effekt på blodkärlen, vilket gör det lättare för blodet att flyta fram och föra med sig livsviktigt syre till våra celler. Denna effekt är ganska logisk eftersom koldioxid produceras i våra celler när näring och syre omvandlas till energi (ämnesomsättning). När ämnesomsättningen är hög, exempelvis i en muskle som vi rör, tillverkas mycket koldioxid samtidigt som behovet av syre i muskeln är stort. Koldioxiden åker ut ur muskeln och vidgar blodkärlen så att blod och syre enkelt kan komma fram och muskeln kan fortsätta arbeta.
- Lungorna renar blodet Lungorna är det enda organ som tar emot allt vårt blod. En av lungornas funktioner är därför att rena blodet. Det passerar 10 gånger så mycket blod i nederdelen av lungorna som uppe vid toppen. Det är därför tänkbart att den låga andning som Relaxatorn ger upphov leder till en ökad rening av blodet.